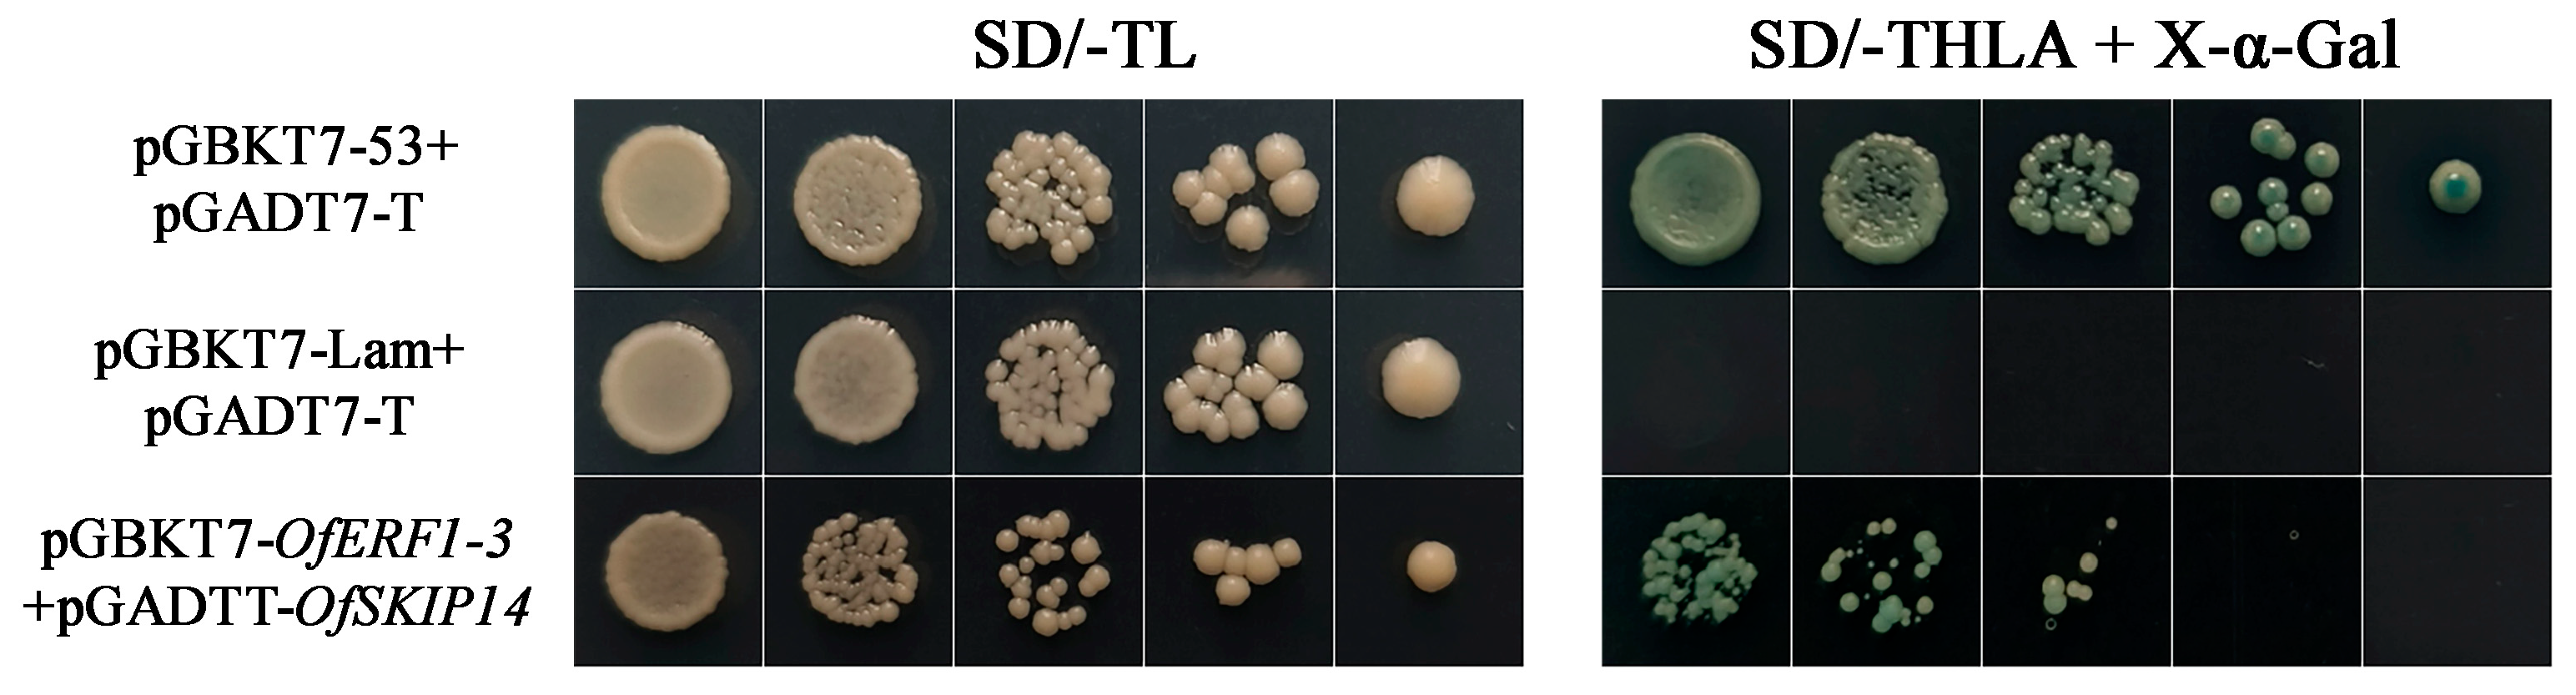
Forests 15 01619 g008

1. Introduction
Osmanthus fragrans, belonging to the genus of Osmanthus within the Oleaceae family, is esteemed as one of the ten historically renowned flowers in China.
O. fragrans boasts a lengthy history of cultivation in China, characterized by a vast distribution range and numerous varieties. Furthermore, it possesses not only esthetic ornamental significance but also serves as a valuable natural spice resource. In recent years, with the gradual deepening of research on sweet osmanthus, it has been recognized for its significant economic value in various sectors such as food, medicine, and daily chemical industries [
1,
2]. The natural blooming season of sweet osmanthus spans from September to October; however, it is noteworthy that the majority of sweet osmanthus varieties exhibit a brief flowering duration, spanning less than one week, with the most favorable harvesting period being confined to a mere 2–3 d [
3]. The brevity of the flowering period significantly influences the esthetic and financial worth of
O. fragrans. Consequently, a pressing concern has emerged regarding how to prolong both the overall duration of flowering and the lifespan of individual blossoms of
O. fragrans.
At the level of individual organisms, senescence is the end of individual plant development, which ultimately leads to death. Senescence is a highly complex phenomenon that must be tightly controlled through different regulatory pathways, and in many cases, these mechanistic pathways are interdependent and complementary [
4]. During the process of plant senescence, the flower is not the sole plant organ that undergoes senescence. Nevertheless, the lifespan of flowers, compared to that of leaves, is comparatively less influenced by environmental factors; therefore, the aging process of petals serves as a significant model for studying the mechanisms that govern senescence [
5]. During the process of flower senescence, numerous morphological and physiological alterations become apparent, facilitating its documentation. The primary indicators of this process are wilting and abscission. Flower senescence is a genetically orchestrated, multifaceted phenomenon that encompasses a series of intricate physiological, biochemical, and molecular transformations. These transformations involve the synthesis and degradation of nucleic acids and proteins, hormonal fluctuations, and the involvement of reactive oxygen species, among other factors [
6]. The progression of petal aging is orchestrated by complex growth and developmental cues, which are transmitted via intricate signaling pathways, ultimately leading to programmed cell death (PCD) [
7]. It has been reported that the biosynthesis and signaling pathways of numerous hormones exert an influence on the process of petal senescence. Ethylene and abscisic acid (ABA) are typically viewed as hormones that promote senescence, whereas cytokinin (CTK) and gibberellin (GA) are commonly perceived as hormones that delay senescence. Additionally, jasmonic acid (JA) has been reported to exert an influence on petal senescence [
8].
A substantial body of experimental evidence has conclusively demonstrated that the type and content of endogenous hormones present in plants, along with their intricate interplay, play a pivotal role in determining the rate of petal senescence. Numerous research studies have consistently demonstrated that ethylene, as a pivotal hormone that governs plant growth and development, holds a crucial position in the process of petal senescence [
9]. Ethylene response factor (ERF), as the component located the furthest downstream within the ethylene signaling cascade, is categorized under the AP2/ERF superfamily of transcription factors. This superfamily exerts pivotal regulatory functions in a broad array of biological and physiological processes, encompassing plant morphogenesis, the orchestration of responses to diverse stress stimuli, and hormone signaling pathways, as well as metabolic regulation mechanisms [
10]. Based on their ability to bind to various cis-acting elements, the ERF family can be categorically divided into two principal subfamilies: the ERF subfamily and the CBF/DREB subfamily. Specifically, the ERF subfamily exhibits the capacity to interact with GCC elements, thereby modulating the expression of genes implicated in plant disease resistance and other signaling cascades. On the other hand, the CBF/DREB subfamily primarily associates with DRE or CRT elements, regulating the adaptive responses of plants to various abiotic stresses, including, but not limited to, low temperature and drought conditions [
11,
12,
13]. In recent years, extensive research has been conducted on the influence of ERF transcription factors on plant growth, development, metabolism, and hormone signaling. The ERF transcription factor family comprises numerous members, each with intricate and varied functions. Unfortunately, the precise roles of individual family members have yet to be definitively elucidated. While it is evident that ERF genes significantly impact plant senescence, the regulatory mechanisms underpinning their involvement in ethylene biosynthesis and transduction remain largely unknown, necessitating further investigation.
Our team has successfully acquired pertinent transcriptome data via the transcriptome sequencing process of
O. fragrans petals across various flowering stages. By meticulously examining the gene family of the AP2/ERF transcription factors, which are intricately linked to the senescence of
O. fragrans, we have identified and selected the relevant genes for functional validation [
14]. In this study, the
OfERF1-3 transcription factor (evm.model.Contig38.70) in
O. fragrans was identified as the primary focus of our investigation. Given the notable upsurge in the expression levels of
OfERF1-3 during the latter stages of the flowering period, it was postulated that this factor might play a pivotal role in a cascade of senescence-related processes in
O. fragrans, thereby influencing the duration of its petal lifespan; however, the question remains unanswered regarding whether
OfERF1-3 impacts petal senescence and the specific regulatory mechanisms involved. Therefore, the objective of this study was to rigorously analyze the function of the
OfERF1-3 gene in
O. fragrans and to preliminarily elucidate its role within the intricate regulatory network that governs petal senescence in this species. The data from this transcriptome or gene expression project have been deposited in the NCBI under the accession number PRJNA1078504.
2. Materials and Methods
2.1. Plant Materials
O. fragrans “Rixianggui”, aged 8–10 years, were planted at Nanjing Forestry University, and they grew robustly. Flowers were collected from each of the five flowering stages during flowering: the linggeng stage (S1), the xiangyan stage (S2), the initial flowering stage (S3), the full flowering stage (S4), and the late flowering stage (S5). All of the collected tissues were frozen in liquid nitrogen and stored at −80 °C until RNA extraction. All of the experiments were conducted at least three times using independently collected and extracted tissues, unless noted otherwise.
2.2. RNA Extraction and qRT-PCR Analysis
The total RNA was isolated using a Trizol reagent kit (TIANGEN, Beijing, China), according to the manufacturer’s instructions. Then, total RNA was reverse-transcribed using One-Step gDNA Removal and cDNA Synthesis SuperMix (TransGen Biotech Co., Ltd., Beijing, China). The concentration of cDNA was diluted to 200 ng·µL
−1. Semi-quantitative PCR was performed using the primers of the internal reference gene, and the quality of the cDNA template obtained was detected (the
OfRAN gene from
O. fragrans was selected as the actin gene) [
15]. The efficacy of reverse transcription was ascertained through agarose gel electrophoresis, and the optimal cDNA template was subsequently selected for further quantitative real-time polymerase chain reaction (qRT-PCR) experimentation. Primer Premier 5.0 software was employed to meticulously design specific primers for each individual gene, and the subsequent expression of these candidate genes was rigorously verified using the qRT-PCR methodology.
The qRT-PCR reaction kit employed was TB Green™ Premium Ex Taq (Takara, Kusatsu, Japan), and the reaction mixture included 5 μL of TB Green Premix Ex Taq II, 0.4 μL of forward primer, 0.4 μL of reverse primer, 0.2 μL of ROX, 1 μL of cDNA, and 3 μL of ddH
2O. The reaction program was set as follows: 95 °C for 3 min, 95 °C for 45 s, 60 °C for 30 s, and 95 °C for 15 s. After 40 cycles of 60 °C for 1 min and 95 °C for 15 s, the data were analyzed using the 2
−∆∆Ct method. The primer sequences employed in this research are enumerated in
Table S1.
2.3. Gene Cloning and Vector Construction
The cDNA of the S4 period of
O. fragrans “Rixianggui” was used as a template. Primers were designed using CE design 1.04 software. The primer sequences were used to amplify the CDS of the
OfERF1-3 gene, as shown in
Table S1. The amplified fragments were confirmed by 1.2% agarose gel electrophoresis and then recovered using a Simgen gel recovery kit (Simgen, Hangzhou, China). The gene was then ligated into the pSuper1300 vector and used to transform competent
Escherichia coli DH5α. The positive colonies were sequenced by the Tsingke Biotech Company (Nanjing, China).
2.4. Bioinformatics Analysis
Using the NCBI (
https://www.ncbi.nlm.nih.gov/ accessed on 1 October 2023) platform, BLAST protein comparisons were rigorously conducted. Subsequently, sequences that exhibited a high degree of similarity to the OfERF1-3 protein were selectively downloaded. To analyze the evolutionary relationships, a phylogenetic tree was meticulously constructed within the MEGA 11 software environment. This tree was formulated by employing the adjacency method (NJ), and its reliability was reinforced through the application of a bootstrap value of 1000. Furthermore, comprehensive multiple-sequence comparisons of the ERF1-3 proteins in
O. fragrans were conducted using DNAMAN 9.0 software, ensuring a comprehensive analysis of the sequences in question.
2.5. Stable Expression of OfERF1-3 in Nicotiana tabacum
According to a previously employed method, the pSuper1300-
OfERF1-3 recombinant plasmid was introduced into the
Agrobacterium tumefaciens strain GV3101. Subsequently,
N. tabacum was genetically transformed by utilizing the leaf disc methodology [
16]. Young tobacco leaves rinsed with purified water were used as explants, and these were then sterilized on an ultra-clean workbench. They were soaked in 75% ethanol for 30 s and then immediately washed three times with sterile pure water. After that, the explants were placed in 5% NaClO for 6 min and rinsed with sterile pure water five to six times. A sterile scalpel was used to excise the leaf margins and veins of the explants, and the rest of the leaves were cut into disks with a diameter of 1 cm. Then, the leaves cut into discs were infiltrated with Agrobacterium for 10 min. After the leaves were infested, they underwent cultivation in a symbiotic medium for a duration of 3 d. Following this, they were transferred to a screening medium, with the medium being replaced every 15 d. When the shoots regenerated and the mature leaves emerged, the independent kanamycin-resistant tobacco plants were then selected and transferred to a rooting medium. When the fibrous roots of plantlets developed and matured, the plantlets were removed from the medium and planted in flowerpots; the plants were then grown in a greenhouse. Control plants were transformed using pSuper1300 empty vector, employing the same methodology. A positive test was utilized to prove that the gene had been overexpressed.
2.6. Transient Expression of OfERF1-3 in O. fragrans Petals
The pSuper1300-OfERF1-3 recombinant plasmid was successfully inserted into the Agrobacterium tumefaciens strain GV3101. Following an overnight incubation period, the cultured Agrobacterium products were carefully transferred into tubes and subjected to centrifugation at 2716× g for a duration of 10 min at a temperature of 4 °C. A solution comprising 10 mM MgCl2, 10 mM MES, and 150 mM acetosyringone was employed to resuspend the Agrobacterium cultures until they achieved an OD600 value within the range of 0.6 to 0.8. The fully bloomed petals of O. fragrans “Rixianggui” were meticulously wrapped in gauze and subsequently subjected to vacuum infiltration with Agrobacterium at a pressure of −0.075 MPa for a period of 15 min. Subsequently, the petals were returned to normal atmospheric pressure, and the vacuum infiltration process was repeated for an additional 15 min. Post infiltration, the petals were gently removed and placed on a 0.5% agar medium, where they were maintained in darkness for a duration of 48 h.
2.7. Physiological Indexes
The malondialdehyde (MDA) content was quantitatively determined by adhering strictly to the TBA method. The methodology involved the precise weighing of 0.1 g of plant tissue, followed by the addition of a concentrated extract solution in a ratio of 1:9, adhering to the weight-to-volume principle. This mixture was homogenized using an internal cutter homogenizer, operating in an ice water bath, with each homogenization cycle lasting between 10 and 15 s at a rotational speed of 8000–10,000 rpm, interspersed with 30 s intervals, for a total of 3–5 cycles. Post homogenization, the homogenate was transferred to a centrifugal tube and centrifuged at a speed ranging from 3500 to 4000 rpm for 10 min. Subsequently, 200 μL of the obtained supernatant was utilized for colorimetric analysis, leveraging the specific colorimetric reaction between the thiobarbituric acid trichloroacetic acid solution and malondialdehyde. For the determination of hydrogen peroxide (H2O2), the titanium sulfate colorimetric method was employed. This process entailed the precise weighing of 0.1 g of tissue and the subsequent addition of 1 mL of acetone-treated samples. The mixture was homogenized in an ice bath, followed by centrifugation at 8000× g for 10 min at a temperature of 4 °C, with the supernatant retained on ice. The quantitative determination of H2O2 content was based on the fundamental principle of yellow titanium peroxide complex formation, which occurs between H2O2 and titanium sulfate.
2.8. Yeast Two-Hybrid Assay
To explore the interactions between OfERF1-3 and other proteins, we conducted rigorous Y2H experiments. Specifically, we constructed a pGBKT7-OfERF1-3 gene vector and subsequently transformed it into E. coli D5α bacteria. The selection and sequencing of positive colonies were carried out. Subsequently, the validation of yeast self-activation was conducted. The pGBKT7-OfERF1-3 plasmid and the pGADT7 plasmid were concurrently introduced into the Y2H yeast strain through co-transfection. Subsequently, the transformed yeast was subjected to observation on an SD/-Trp/-His/-Leu/-Ade yeast screening medium to ascertain its growth capacity. This assessment was performed to determine whether the inclusion of AbA would be necessary in subsequent screen library experiments to suppress potential transcriptional self-activation. It has been observed that OfERF1-3 exhibits no self-activating properties. Subsequently, the pGBKT7-OfERF1-3 construct was co-transfected alongside the yeast library plasmid into a Y2H yeast strain. This mixture was then plated onto an SD/-Trp/-Leu/X-α-Gal medium and incubated at 30 °C for a period of 2–3 d. The initial screening process involves inoculating Y2H strains containing AD and BD vectors onto SD/-Leu-Trp-His-Ade plates, followed by cultivation at a controlled temperature of 30 °C for a period of 3–5 d. Subsequently, blue-positive clones identified on the primary screening plate were meticulously selected for transfer to a secondary screening medium, specifically SD/-Trp/-Leu/-His/-Ade/X-α-Gal. These clones were then incubated at 30 °C for an additional 3–5 d. Upon completion of the incubation period, blue-positive clones were chosen for further sequence analysis. The sequencing process aims to determine the sequences of potential reciprocal genes, ultimately leading to the selection of candidate genes. To construct a pGADT7-OfSKIP14 recombinant plasmid, the Y2H yeast strain was co-transfected with the pGBKT7-OfERF1-3 plasmid. Following this, the transformed yeast was spread onto an SD/-Trp/-Leu/-His/-Ade/X-α-Gal plate and incubated in an incubator for a period of 3 to 5 d. During this incubation period, it was anticipated that blue-positive clones would emerge and grow on the plate.
2.9. Experimental Design and Data Analysis
The gene
OfERF1-3, which was chosen for the study, was selected based on ERF transcriptome data and changes in expression at each
O. fragrans flower stage. qRT-PCR experiments were then performed to verify the accuracy of the transcriptome data. The OfERF1-3 protein was analyzed on the NCBI (
https://www.ncbi.nlm.nih.gov/ accessed on 1 October 2023) platform in order to download related similar sequences. MEGA 11 software was used to construct a phylogenetic tree, and multiple-sequence comparisons were performed using DNAMAN software. The
OfERF1-3 gene was overexpressed in
N. tabacum and
O. fragrans. The function of the
OfERF1-3 gene in the senescence process of
O. fragrans petals was verified by observing the plant phenotype, comparing the expression of senescence marker genes, and measuring physiological indexes. A yeast two-hybrid assay was used to search for proteins that interact with
OfERF1-3, and the senescence regulatory network of
Osmanthus fragrans was explored more deeply.
4. Discussion
The plant ethylene response factor (ERF) constitutes a subfamily within the AP2/ERF superfamily and is instrumental in the regulation of plant growth and floral development. Ethylene is known to play a pivotal role in the modulation of banana fruit ripening. A total of 15 ERF genes, designated as
MaERF1 to
MaERF15, were isolated and characterized from banana fruits. It was demonstrated that these MaERF genes play a role in fruit ripening by transcriptionally regulating ethylene biosynthesis genes or through interactions with them [
17]. A total of 13 members of the AP2/ERF superfamily have been identified in petunias, and it has been observed that these
PhERFs display distinct expression patterns in the corolla and calyx throughout the natural senescence of petunia flowers [
18]. Here, we identified and characterized a senescence-related gene,
OfERF1-3, from sweet osmanthus. The phylogenetic tree analysis revealed that OfERF1-3 and the OeERF1-3 from
O. europaea var. sylvestris are positioned the closest to each other. In
A. thaliana, OfERF1-3 exhibits a high degree of homology with AtERF1-3. Amino acid comparisons indicated that the structure of OfERF1-3 is highly conserved and shares a conserved structural domain of the ARF/ERF superfamily with AtERF1-3 and OeERF1-3.
The expression patterns of a gene can reflect its function, to some extent. Genes related to flower senescence have been reported to display differential gene expressions at different stages of flower development. During wintersweet flower development, the obvious expression of
CpSRG1 was detected from stage 3 (petal-display period) to stage 5 (bloom period), and it reached the highest expression at stage 6 (withering period), which indicated that
CpSRG1 may play roles in flower development and senescence in wintersweet [
19]. The transcript levels of
PhOBF1 continued to increase in the detached flowers of both the “Mitchell Diploid” and “Primetime Blue” petunia cultivars from anthesis (D0) to 7 days after anthesis (D7) [
20]. In the current investigation, we identified
OfERF1-3 genes exhibiting notably elevated expressions at the late flowering stage, building upon our prior analysis of the AP2/ERF transcription factor gene family associated with senescence in
O. fragrans [
14]. The expression consistency was confirmed through sequencing results using qRT-PCR. These results indicated that
OfERF1-3 may play roles in flower development and senescence in
O. fragrans.
It is commonly believed that increased expression of the ethylene response factor (ERF) gene accelerates plant senescence. For example, the
PhERF71 gene has been identified as a positive regulator of floral senescence in petunias, functioning by modulating the biosynthesis of ethylene [
21]; however, there are also ERF genes that act as reverse regulators of the plant senescence process, and their overexpression can delay plant senescence.
SlERF.F5 has been demonstrated to directly modulate the promoter activity of
ACS6 and to interact with
SlMYC2 in order to regulate leaf senescence in tomato plants. The silencing of
SlERF.F5 causes accelerated senescence induced by age, darkness, ethylene, and jasmonic acid [
22]. In
Rosa hybrida, RhERF113 delays ethylene-induced flower senescence by increasing the CTK content of the floral tissues [
23]. Arabidopsis plants overexpressing
AtERF019 exhibit delayed plant growth and senescence, showing a delay in flowering time of 7 days and a delay in senescence of 2 weeks when compared with the results for the wild-type plants [
24]. In our study, we demonstrated, through various aspects, that
OfERF1-3 can delay petal senescence. We hypothesize that the
OfERF1-3 gene may be similar to some ERFs in other species, which are able to influence the synthesis and conductance of other hormones. This gene is able to influence the
OfERF1-3 senescence process, in combination with other hormones, ultimately leading to delayed petal senescence. Combined with the analyses of previous studies, these results also increased the credibility of the study.
SAG12 is a cysteine protease-encoding gene from
A. thaliana that is exclusively expressed in senescent tissues, rendering it a broad indicator of senescence [
25]. The
SAG12 promoter is typically activated in aging leaves. Nevertheless, a distinct domain of
SAG12 expression has also been identified in the senescent flowers of
N. tabacum [
26]. The upregulation of 1-aminocyclopropane-1-carboxylic acid oxidase (ACO) transcripts has been observed to coincide with the opening and senescence of tobacco flowers [
27]. In our study, we investigated the expression of the senescence marker genes
NtSAG12 and
NtACO1 in petals of
OfERF1-3-overexpressing transgenic tobacco. It is evident that the expression of these senescence marker genes in the petals of the overexpressing plants, compared to that observed in the wild type, was markedly diminished at the full flowering stage and thereafter. This suggests that
OfERF1-3 decelerates the senescence process of petals in tobacco. The
SAG21 gene in
A. thaliana was initially discovered to be upregulated during leaf senescence, peaking in abundance before full senescence, and then decreasing at the onset of visible senescence or shortly thereafter. Interestingly, it was also found to be highly expressed in petals [
28]. In a study on flower senescence in
O. fragrans,
OfACS1 expression was significantly elevated in early senescence compared to during full bloom [
29]. In
OfERF1-3-overexpressing transgenic
O. fragrans petals, the senescence marker genes
OfSAG21 and
OfACS1 were notably reduced at the full bloom stage compared with the levels in the control. These findings imply that
OfERF1-3 plays a role in regulating the senescence process of
O. fragrans petals and enhancing its resistance to aging.
Lipid peroxidation arises from the oxidative breakdown of polyunsaturated fatty acids, a process that can occur through auto-oxidation or via reactive oxygen species (ROS), particularly during the aging process. This degradation leads to the formation of numerous oxidation products, including malondialdehyde (MDA) [
30]. MDA serves as a marker for lipid peroxidation within cell membranes, acting both as a byproduct of peroxidation and as a potent reactant with various cellular components, potentially inflicting significant harm on enzymes and membrane systems. Research on the development and senescence of
F. hybrida flowers has shown that MDA levels in tepals escalate as development and senescence advance [
31]. Among the reactive oxygen species (ROS), H
2O
2 plays a pivotal role in governing plant development and responses to environmental stimuli, and it is regarded as a crucial signaling molecule that mediates various physiological and biochemical processes in plants [
32,
33]. The necessity of H
2O
2 for the effective initiation and progression of the senescence program has been demonstrated [
34]. Elevated intracellular H
2O
2 levels in
A. thaliana and
B. napus are correlated with the initiation of senescence [
35]. It has been observed that a rise in endogenous H
2O
2 levels and a reduction in antioxidant enzyme activities may partially trigger senescence in rose petals [
36]. In the present study, the levels of MDA and H
2O
2, indicators of oxidative stress, were found to be lower in
OfERF1-3-overexpressing tobacco petals compared to those noted in the wild type, suggesting a reduction in plant senescence. These findings imply that the
OfERF1-3 gene has the potential to delay petal senescence.
The regulation of ABA-induced leaf senescence is achieved, in part, by the citrus protein
CsHB5, which directly controls the accumulation of ABA [
37]. In the floral context, ABA influences the senescence of petals in both ethylene-sensitive and ethylene-insensitive plants [
38,
39].
DcWRKY33, a well-known ethylene-sensitive cut flower worldwide, has been identified to facilitate petal senescence by activating the genes responsible for ethylene and ABA synthesis, as well as ROS (reactive oxygen species) accumulation in carnations [
40]. In the case of the ethylene-insensitive gladiolus, the application of exogenous ABA hastened the senescence of flowers, and the increase in endogenous ABA levels within the petals, induced by osmotic stress, also upregulated the parameters associated with natural senescence [
41]. Through protein interaction assays, our study revealed that the OfERF1-3 protein can interact with OfSKIP14. SKIP (SKI-interacting protein) is a highly conserved protein that participates in transcriptional regulation and RNA splicing, playing a crucial role in plant growth, development, and stress responses. Research on
A. thaliana has shown that SKIP not only impacts the development and growth of a plant but also enhances resistance to abiotic stress by modulating ABA signaling, with plants overexpressing
AtSKIP exhibiting increased insensitivity to ABA [
42]. Furthermore, it has been discovered that SKIP acts as a splicing factor that positively regulates ABA signaling in
A. thaliana [
43]. Consequently, we hypothesize that OfERF1-3 may modulate the ABA signaling pathway by interacting with OfSKIP14, thereby influencing the senescence of
O. fragrans petals. The precise regulatory mechanism awaits further elucidation, presenting a potential focus for subsequent research.